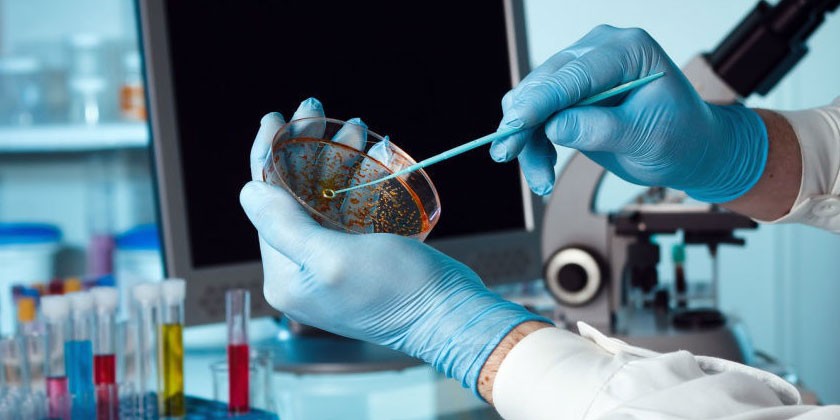
image

Одними из важнейших компонентов пищи и главными поставщиками энергии для тела являются углеводы. При нарушении процесса их усвоения (мальабсорбции), спровоцированной приобретенной либо врожденной ферментативной недостаточностью, наблюдается общее ухудшение состояния здоровья человека. Лабораторный анализ кала на содержание углеводов позволяет диагностировать различные патологии и назначить эффективную терапию, избавляющую пациента от неприятных симптомов.
Что такое углеводы в кале
Существует лабораторное исследование каловых масс, после расшифровки результатов которого устанавливается количественное содержание в фекалиях сахаров, дисахаров, поли- и моносахаридов, мальтозы. При выявлении этих веществ проводится дальнейшая диагностика пациента для установления причин патологического процесса. Лабораторное исследование, как правило, применяется для установления наличия лактозной непереносимости у новорожденных и детей на первом году жизни.
Мнение врача:
При анализе уровня углеводов в кале важно учитывать, что небольшое количество углеводов в кале может быть нормой, но высокий уровень углеводов может свидетельствовать о проблемах с пищеварением, таких как мальабсорбция или сахарный диабет. Врачи рекомендуют обратить внимание на питание, чтобы избежать излишнего потребления углеводов, и при необходимости пройти дополнительные обследования для выявления возможных причин высокого уровня углеводов в кале.
https://youtube.com/watch?v=O5Ue-vv1f4U
Анализ кала на углеводы
В основе исследования лежит способность простых углеводов выступать катализатором разных химических реакций. Эти вещества восстанавливают катионы меди, которые входят в состав неорганических и органических соединений. По ходу химической реакции происходит изменение цвета компонента, благодаря чему лаборант может делать выводы о наличии в биообразцах поли- и моносахаридов.
После извлечения кала из стерильной емкости в него добавляют немного дистиллированной воды. Далее материал подвергается центрифугированию, его смешивают с химическим реактивом. По тому, как изменилась окраска, можно судить о количественном содержании углеводов в кале:
|
Цвет |
Концентрация углеводов |
|
Зеленый |
Больше 0,05% |
|
Желтый |
0,5% и выше |
|
Красный |
Более 2% |
Если цвет кала при соединении с реактивом сохранил свой исходный светло-голубой окрас, то причина расстройств пищеварения не связана с неправильной абсорбцией углеводов. Чтобы получить максимально достоверные результаты анализа, важно не изменять привычный рацион питания, не соблюдать какую-либо диету накануне сдачи материала в лабораторию.
Интересные факты
-
Углеводы в кале могут указывать на наличие пищевой непереносимости или аллергии.Если в кале присутствует большое количество непереваренных углеводов, это может быть признаком того, что организм не усваивает определенные виды пищи. При пищевой непереносимости или аллергии организм не вырабатывает ферменты, необходимые для расщепления углеводов, что приводит к тому, что они остаются в кишечнике непереваренными.
-
Углеводы в кале также могут быть признаком нарушения функции поджелудочной железы.Поджелудочная железа вырабатывает ферменты, необходимые для переваривания углеводов, белков и жиров. Если функция поджелудочной железы нарушена, она может не вырабатывать достаточного количества ферментов, что приводит к тому, что углеводы не усваиваются и остаются в кале в непереваренном виде.
-
Углеводы в кале у детей могут быть признаком целиакии, врожденного аутоиммунного расстройства.При целиакии организм вырабатывает антитела, которые атакуют стенки тонкого кишечника, вызывая воспаление и повреждение. Это может приводить к нарушению всасывания питательных веществ, в том числе углеводов, что приводит к их появлению в кале.

Показания к проведению анализа
Выявление углеводов в фекалиях может быть самостоятельным диагностическим исследованием или проводится в комплексе с другими анализами. Как правило, вместе с этим проводится копрограмма кала, исследования фекалий для обнаружения дисбактериоза, генетические маркеры лактазной недостаточности. Биохимический анализ не проводят детям на протяжении первых 3 месяцев жизни, поскольку в это время процессы пищеварения лишь начинают формироваться, и результат будет неинформативным. Показаниями для проведения исследования являются:
- боли в животе;
- частые срыгивания;
- плохая прибавка в массе у ребенка;
- понос;
- дисбактериоз кишечника;
- повышенное газообразование, вздутие живота;
- запор.
Опыт других людей
Углеводы в кале могут быть признаком неполной усвояемости пищи. Это может быть связано с неправильным питанием, стрессом или заболеваниями ЖКТ. Важно обратить внимание на этот анализ и проконсультироваться с врачом для выявления причины. Не стоит паниковать, но и игнорировать результаты не стоит. Здоровье всегда важнее.
Подготовка
Чтобы в результате исследования каловых масс на наличие углеводов получить достоверные результаты, важно правильно подготовиться к сдаче анализа. Для этого врачи рекомендуют:
- за 3 суток до этого исключить использование ректальных свечей, не делать очистительных клизм;
- за неделю до процедуры отменить прием медикаментов, способных повлиять на характер стула (стимулировать диарею, запор), повышающих перистальтику, содержащих красители;
- за сутки до исследования не менять привычный рацион, но отказаться от алкоголя и ярких, красящих овощей и фруктов типа свеклы, спаржи, пр.;
- за 2-3 дня до сдачи образца не проходить диагностические исследования с использованием контрастных веществ (МРТ, КТ, пр.).
Статьи по теме
- Зеленый кал у взрослого – почему появляется и на какие болезни указывает, методы обследования и терапия
- Дрожжевые грибы в кале у взрослого при анализе
- Дрожжевые грибы в кале у ребенка – симптомы и проявления, методы терапии и профилактики
Как сдать анализ кала
Если берется кал на углеводы у грудничка, нежелательно брать образец с поверхности подгузника, поскольку жидкая часть фекалий, которая необходима для исследования, впитывается абсорбентом внутри одноразовых трусиков. Для взрослых процедура сбора материала для анализа такая:
- опорожняют мочевой пузырь;
- проводят гигиенические процедуры для наружных половых органов и анального выхода кипяченой водой с использованием мыла (средство должно быть без красителей или ароматизаторов);
- после дефекации кал собирают специальным шпателем в сухой чистый контейнер с крышкой (купить его можно в аптеке);
- количество биологического материала может варьироваться, но его должно быть не меньше 1 ч. л.;
- образцы берутся из средней части фекалий, при этом берут лишь разжиженные массы;
- не рекомендуется собирать образцы прямо из унитаза: если на них попадет вода – это станет причиной получения некорректных результатов;
- после сбора биоматериала контейнер плотно закрывают крышкой, указывают на нем свои данные (ФИО, возраст, дату сбора) и на протяжении 4 часов кал необходимо принести в лабораторию, где будет проведено исследование.

Расшифровка
Уровень углеводов в каловых массах определяется в процентах. Результаты анализа отличаются у детей разных возрастов и взрослых. Зачастую причиной неблагоприятных показателей является дисбактериоз либо незрелость ферментативных систем. При этом врач-педиатр проводит лечебные мероприятия и осуществляет коррекцию микробиологических нарушений в кишечнике малыша. Лабораторные исследования кала могут назначаться также взрослым, при этом частой причиной наличия углеводов в фекалиях является недостаток панкреатических ферментов.
Норма содержания углеводов в кале
Идеальный вариант – это отсутствие углеводов в каловых массах детей и взрослых, что указывает на нормальное состояние здоровья. Даже у сладкоежек осуществляется расщепление этих органических веществ, а после – абсорбция продуктов их метаболизма. Углеводы подвергаются переработке уже на этапе попадания в ротовую полость посредством ферментов в слюне. По ходу прохождения пищи по ЖКТ (желудочно-кишечному тракту) они усваиваются полностью.
В фекалиях у взрослого углеводов быть не должно, иначе фиксируется патологическое состояние и назначаются дополнительные обследования. Норма углеводов в кале у грудничка до 12 месяцев – это 0-0,25%. Превышающие эти цифры показатели являются отклонением от нормы. При этом, если анализ показал результат 0,3-0,5% – это незначительное отклонение, а при показателях 0,6-1% фиксируют среднее отклонение. Если в кале содержится 1% и более углеводов, такое отклонение считается существенным. Нормы содержания углеводов в кале у деток по визуальным характеристикам:
|
Допустимые показатели |
Дети на грудном вскармливании |
Дети на искусственном вскармливании |
Дети старше года |
|
Суточное количество кала |
40-50 г |
30-40 г |
100-250 г |
|
Консистенция |
Кашеобразная, клейкая, вязкая |
Замазкообразная |
Оформленная |
|
Цвет |
Желтый, желто-зеленый |
Желто-коричневый |
Коричневый |
Повышенное содержание углеводов
Превышение показателей количества сахаров в кале допускается лишь у маленьких деток. Норма углеводов в фекалиях у них варьируется от 0,001 до 0,25%. Если у малыша не наблюдается проблем с аппетитом и происходит активный набор веса, педиатры не считают отклонением и 0,5-0,6%. В случаях, когда зафиксировано более значительное повышенное содержание углеводов в кале у грудничка, возникает необходимость дальнейшего обследования ребенка на предмет лактазной недостаточности.
Причины отклонений
Превышение допустимого количества углеводов в каловых массах характерно для лактазной недостаточности, кроме того, это может указывать на нарушение усвоения других сахаров. Анализ может показать ложноположительный результат, если ребенок незадолго до него принимал аскорбиновую кислоту, антибиотики, салицилаты, другие препараты. Кроме этого, недостоверный результат можно получить, если ребенок перед анализом кушал низколактозную смесь.
При низком и среднем отклонениях от нормы содержания углеводов в фекалиях ребенка, за пациентом продолжают наблюдать и со временем назначают тест на кислотность и еще одно исследование. При показателе углеводов выше 1% и наличии определенной клинической картины у малыша диагностируют дефицит лактазы и назначают лечение. Содержание углеводов в кале может объясняться наличием других патологических факторов, включая:
- хронические патологии тонкого кишечника, включая болезнь Крона (воспаление ЖКТ гранулематозного типа), целиакия (отсуствие корректного расщепления глютена);
- вторичная мальабсорбция приобретенного вида (развивается после перенесенных кишечных инфекций, операций на органах ЖКТ);
- приобретенная недостаточность сахарозо-изомальтазного комплекса, которая выражается диспепсией (нарушением пищеварительного процесса) после употребления злаков, продуктов с солодом, крахмалом.

Видео
Внимание!
Информация, представленная в статье, носит ознакомительный характер. Материалы статьи не призывают к самостоятельному лечению. Только квалифицированный врач может поставить диагноз и дать рекомендации по лечению, исходя из индивидуальных особенностей конкретного пациента.
Частые вопросы
Какие углеводы обычно анализируются в кале?
Обычно в кале анализируются различные виды углеводов, такие как клетчатка, крахмал и сахара.
Зачем проводится анализ углеводов в кале?
Анализ углеводов в кале может помочь в диагностике различных заболеваний, таких как сахарный диабет, болезни желудочно-кишечного тракта и дисбактериоз.
Полезные советы
СОВЕТ №1
При анализе содержания углеводов в кале обратите внимание на тип углеводов: простые (быстрые) и сложные (медленные). Это поможет вам понять, какие продукты лучше усваиваются и не вызывают резких скачков уровня сахара в крови.
СОВЕТ №2
Изучите соотношение углеводов, белков и жиров в своем рационе. Это поможет вам понять, какие продукты стоит уменьшить или увеличить в своем питании для достижения оптимального баланса питательных веществ.
